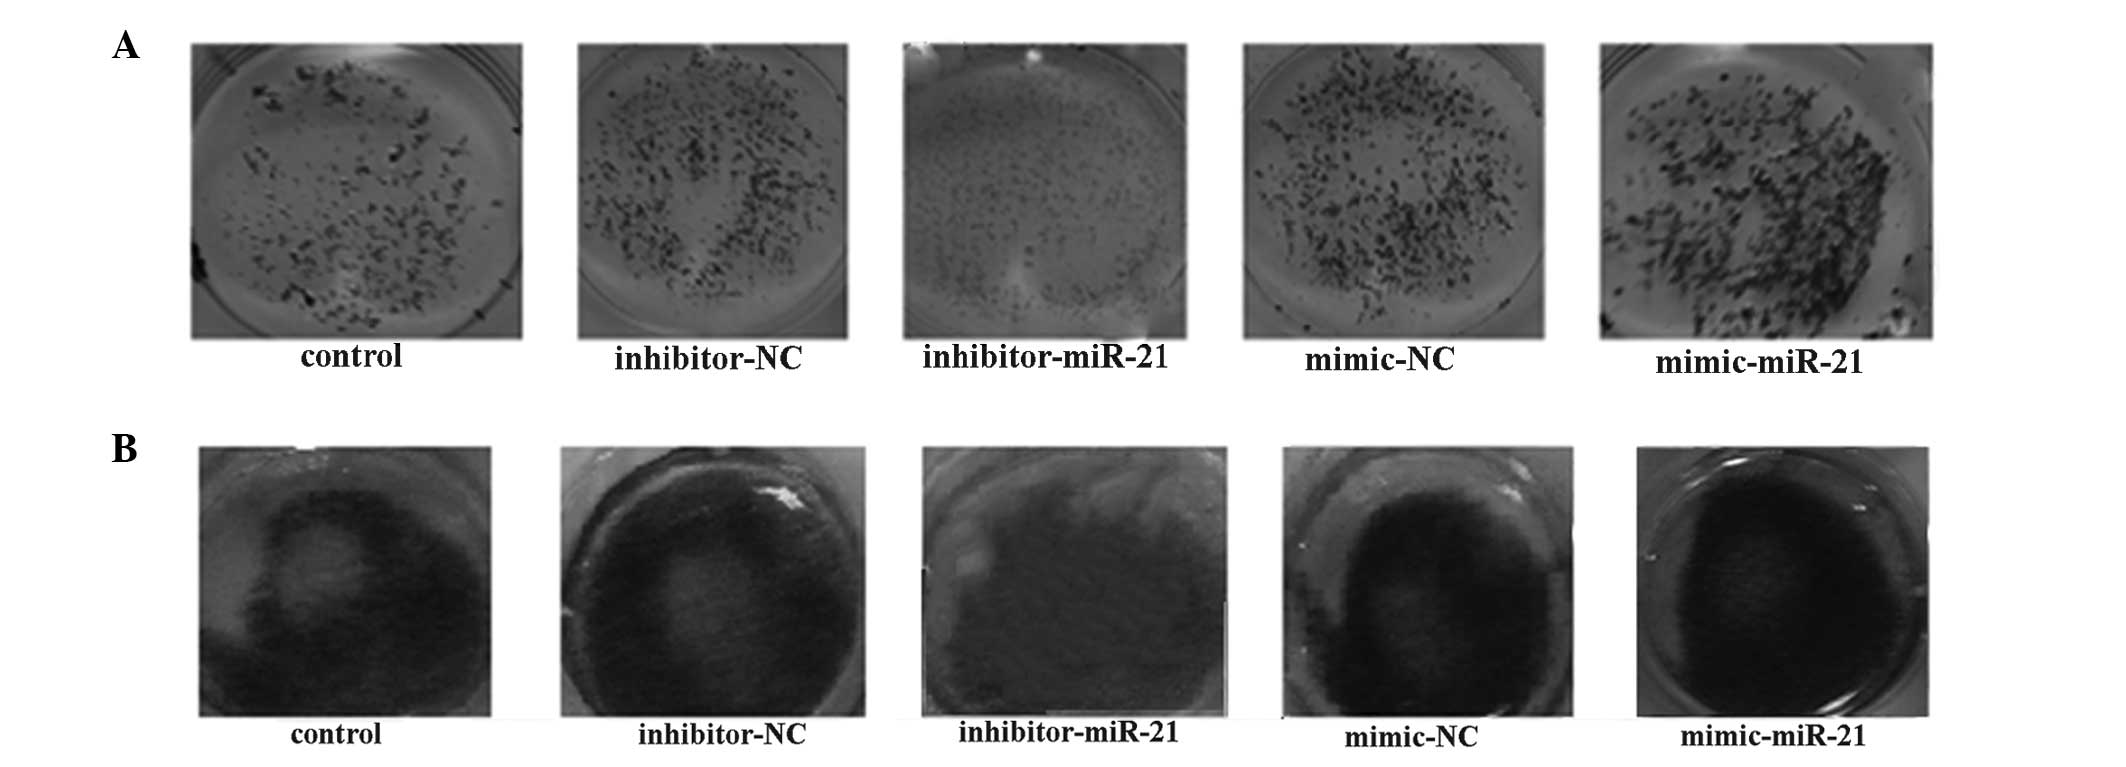
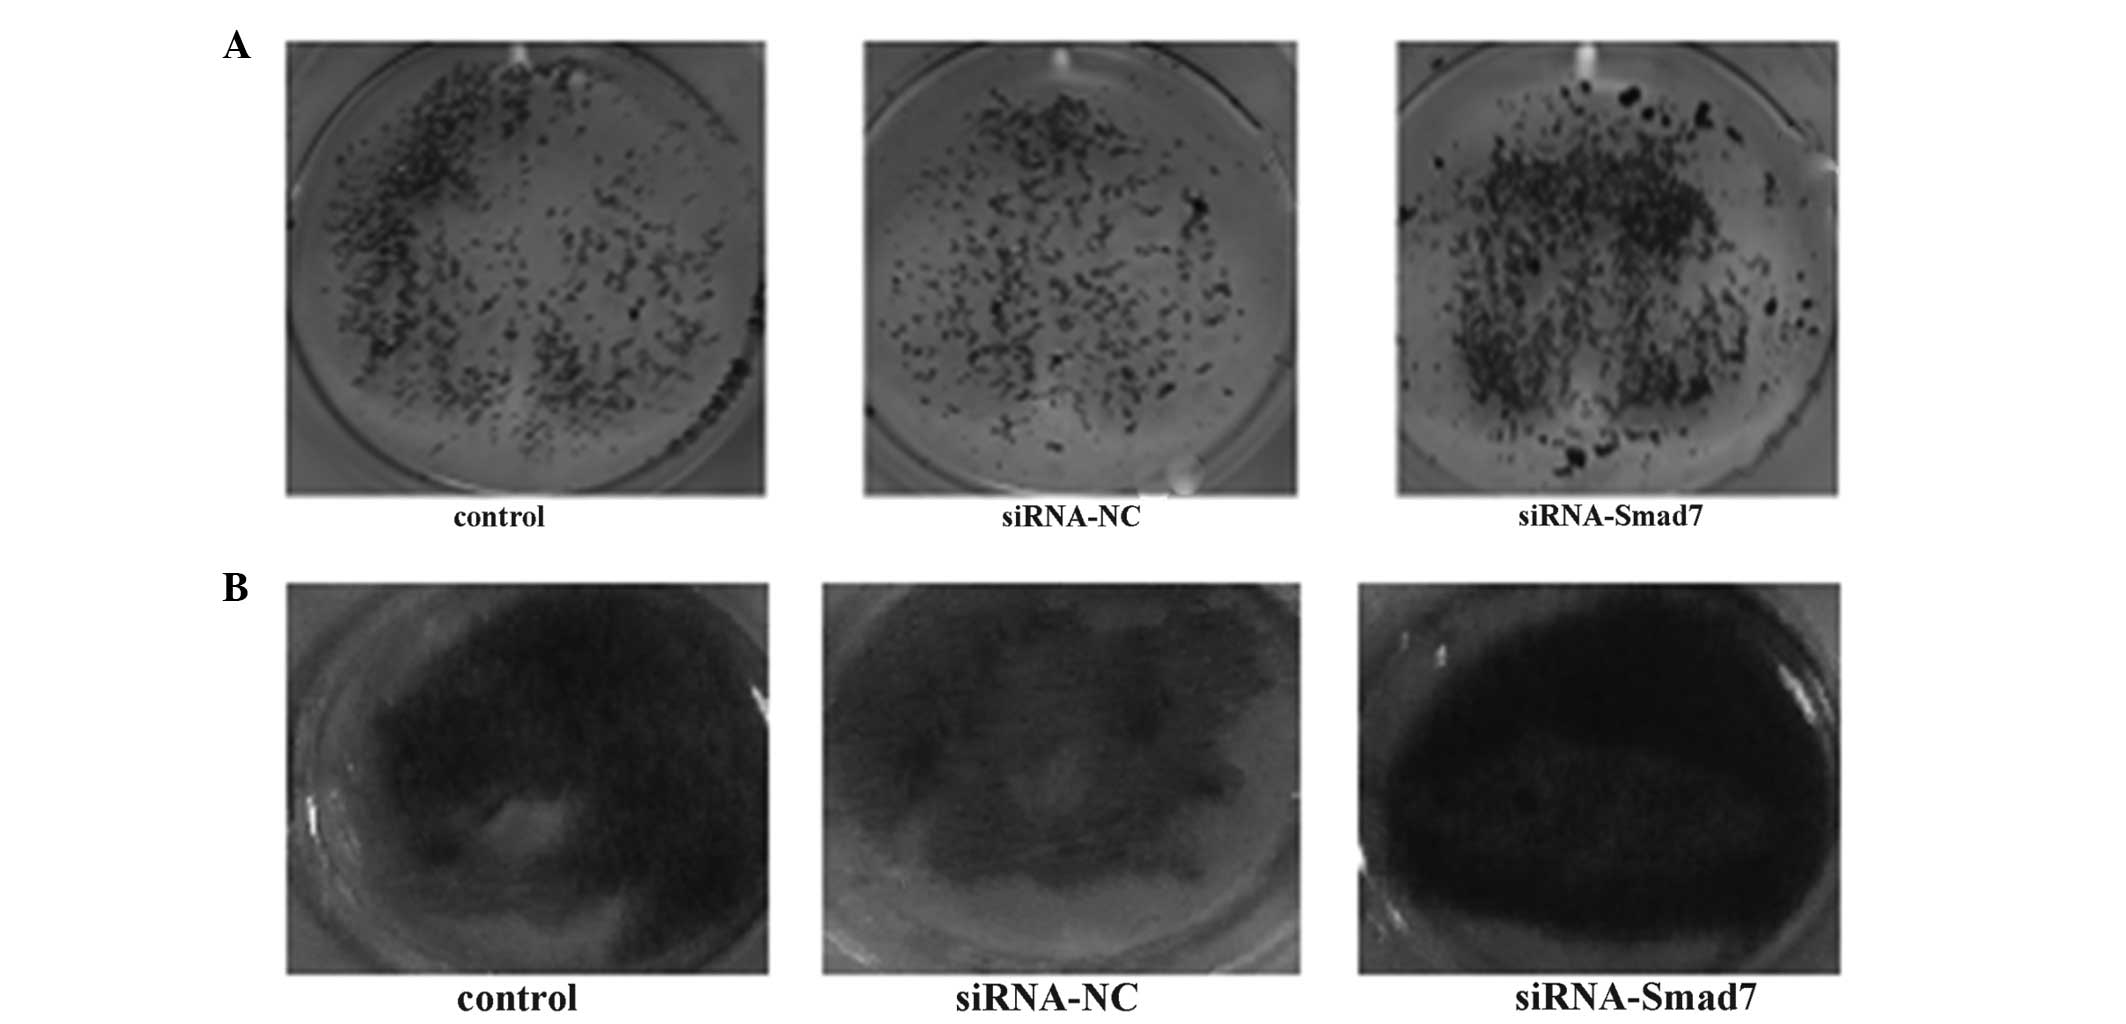

Introduction
MicroRNAs (miRNAs/miRs) are short, noncoding RNAs,
which are critical in numerous biological processes due to their
regulation of gene expression. miRNAs suppress target gene
expression by sequence-specific binding to 3′-untranslated regions
(UTRs) of target mRNAs, thereby inducing mRNA degradation or
translation inhibition (1).
Previous studies have suggested that miRNAs may be
important in bone formation (2)
and may positively or negatively control osteogenic differentiation
and mineralization by targeting negative regulators of osteogenesis
or important osteogenic factors, respectively. miR-542-3p inhibits
osteoblast proliferation and differentiation, suppresses osteogenic
differentiation and promotes osteoblast apoptosis by repressing
bone morphogenetic protein (BMP)7 and its downstream signaling
(3). miR-335-5p directly targets
and downregulates the Wnt inhibitor, DKK1, to enhance Wnt signaling
and promote osteogenesis (4).
miR-15b promotes osteogenic differentiation by indirectly
protecting the Runt-related transcription factor 2 (Runx2) protein
from small mothers against decapentaplegic (SMAD)-specific E3
ubiquitin protein ligase 1-mediated degradation (5).
The transforming growth factor (TGF)-β family
members, bone morphogenetic protein (BMP)2 and TGF-β, which signal
via receptor-regulated Smads (R-SMADs), induce bone formation
(6). To understand the role of
miRNAs in osteoblasts, several miRNAs that are modulated by
TGF-β/SMAD signaling, including miR-15b (5), miR-142-3p (7) and miR-322/503 (8), have been investigated. SMAD7 also
interacts with all subfamilies of activated type I receptors and
inhibits BMP and TGF-β signaling. SMAD7 is a critical regulator of
osteogenic differentiation, which inhibits the proliferation,
differentiation, and mineralization of mouse osteoblastic cells
(9).
miR-21 regulates cell proliferation, survival and
migration in numerous types of cancer and is involved in other
diseases, including asthma (10),
coronary plaque instability (11),
and intervertebral disc degeneration (12). Yang et al (13) demonstrated the role of miR-21 in
estrogen deficiency-induced osteoporosis, and confirmed that it
promotes osteoblast differentiation. However, the association
between miR-21 and Smad7 in osteoblast differentiation
remains to be elucidated. The present study aimed to investigate
whether miR-21 targets Smad7 in vitro and is involved in
osteogenic differentiation and mineralization. It also aimed to
investigate whether miR-21 alters levels of SMAD7 through
translation inhibition or mRNA decay.
Materials and methods
Cell culture and osteogenic
differentiation
The MC3T3-E1 cell line, derived from murine
calvaria, was obtained from American Type Culture Collection
(Manassas, VA, USA). The MC3T3-E1 cells were seeded at a density of
2×104 cells/cm2 and cultured in α-modified
Eagle’s minimum essential medium (Invitrogen Life Technologies,
Carlsbad, CA, USA) with 10% fetal bovine serum (Mediatech, Inc.,
Manassas, VA, USA), 100 U/ml penicillin and 100 mg/ml streptomycin
(Sigma-Aldrich, St. Louis, MO, USA) at 37°C and 5% CO2.
For osteogenic differentiation, the MC3T3-E1 cells were plated in
24-well plates with medium containing 50 μg/ml ascorbic acid
(Sigma-Aldrich), 10 mM β-glycerol-phosphate (Sigma-Aldrich), and 10
nM dexamethasone (Sigma-Aldrich).
Transfection
The MC3T3-E1 cells were transfected with either
mimic-miR-21 (RiboBio, Guangzhou, China), inhibitor-miR-21
(RiboBio, Guangzhou, China), or short interfering (si)RNA-Smad7
(Invitrogen Life Technologies) using Lipofectamine® 2000
(Invitrogen Life Technologies), according to the manufacturer’s
instructions.
Reverse transcription-quantitative
polymerase chain reaction (RT-qPCR)
RNA was extracted from the MC3T3-E1 cells
(1×106 cells) using TRIzol reagent (Invitrogen Life
Technologies) and cDNA was generated via RT. The miRNAs were
purified using an All-in-One microRNA extraction kit (GeneCopoeia,
Rockville, MD, USA), according to the manufacturer’s instructions.
qPCR was performed using an ABI StepOne Plus real-time PCR system
(Applied Biosystems, Foster City, CA, USA). The primers used are
listed in Table I. The relative
expression levels of miR-21 were calculated using the
2−ΔΔCT method (14), in
which ΔCT was defined as the threshold cycle (CT) value of the U6
internal control minus the CT value of the target miRNA. The
expression levels of Smad7, alkaline phosphatase (ALP),
Runx2, osteocalcin (OCN), and osterix (OSX)
were normalized against β-actin and calculated using the
2−ΔΔCT method.
 | Table IPrimer sequences used in reverse
transcription-quantitative polymerase chain reaction. |
Table I
Primer sequences used in reverse
transcription-quantitative polymerase chain reaction.
| Gene | Forward primer | Reverse primer | Length (bp) |
|---|
| β-actin |
5′-AGATGTGGATCAGCAAGCAG-3′ |
5′-GCGCAAGTTAGGTTTTGTCA-3′ | 20 |
| Smad7 |
5′-CTGCAGCGGCCAATGACCA-3′ |
5′-ATGAGCCTCTCAGCCGGGGG-3′ | 19 |
| ALP |
5′-GCAGCTTGGTGCACACCTAG-3′ |
5′-GAGACATTTTCCCGTTCACC-3′ | 20 |
| RUNX2 |
5′-CCGGCAAGATGAGCGAGGTCA-3′ |
5′-GTGGGTTGAGAAGCGGCTCT-3′ | 21 |
| OCN |
5′-ATGAGGACCCTCTCTCTGCT-3′ |
5′-GGAGCTGCTGTGACATCCAT-3′ | 19 |
| OSX |
5′-AGCGACCACTTGAGCAAACAT-3′ |
5′-GCGGCTGATTGGCTTCTTCT-3′ | 21 |
Target prediction
The Target Scan (http://www.targetscan.org), PicTar (http://pictar.bio.nyu.edu) and miRanda (http://www.microrna.org) target prediction tools were
used to screen for the miR-21 target genes.
Mineralization
For the investigation of mineralization, ALP
(Sigma-Aldrich) and alizarin red staining (ARS; Sigma-Aldrich) were
performed. To measure the formation of bone nodules, the
extracellular matrix calcium deposits were stained using 0.2% ARS
for 30 min, as previously described (3–5). The
mineralization values were normalized to the relative value of the
control.
Western blot analysis
The cells (1×106) were lysed in lysis
buffer (pH 7.5), containing 50 mM Tris, 0.1% SDS (Bio-Rad
Laboratories, Inc., Hercules, CA, USA), 250 mM NaCl, 2 mM
dithiothreitol, 1 mM phenylmethylsulfonyl fluoride, 0.5% NP-40 and
protease inhibitor cocktail). Western blotting was performed,
according to the manufacturer’s instructions (Santa Cruz
Biotechnology, Inc., Santa Cruz, CA, USA). Equal quantities of
protein (100 μg) were separated on 8–10% polyacrylamide-SDS
gels. The proteins were then transferred onto polyvinylidene
difluoride membranes (Bio-Rad Laboratories, Inc.). The activation
of SMAD7 was detected using a mouse monoclonal anti-phospho-SMAD7
IgG antibody (1:500; sc-365846; Santa Cruz Biotechnology,
Inc.).
Luciferase assays
The 3′-UTR of Smad7 was amplified using the
following primers from Invitrogen Life Technologies: Sense
5′-TTTTTCTAGACCGCGTGCGGAGGGGACAGA-3′ and antisense
5′-TTTTTCTAGAGGAGTCCTTTCTCTCTCAAAGC-3′. The fragment was inserted
into the XhoI and NotI restriction sites of psiCHECK2
(Promega, Madison, WI, USA). Mutations in the miR-21 binding site
module of Smad7 were introduced by whole-plasmid
amplification in the seed region of miR-21 (New England Biolabs,
Ipswich, MA, USA). The MC3T3-E1 cells were transfected with either
the wild-type (WT) Smad7 3′-UTR or the mutant Smad7
3′-UTR (Mut), in combination with either the miR-21 mimic or the
control mimic-negative control (NC). The cells were collected 48 h
after transfection, and luciferase activity was measured using a
Dual-Luciferase Reporter Assay system (Promega).
Statistical analysis
Data are presented as the mean ± standard deviation.
Comparisons between groups were analyzed with a paired sample
t-test using SPSS 13.0 software (SPSS, Inc., Chicago, IL, USA).
P<0.05 was considered to indicate a statistically significant
difference.
Results
miR-21 promotes osteogenic
differentiation and mineralization
To investigate the role of miR-21 in osteogenic
differentiation, the MC3T3-E1 cells were differentiated and the
expression of miR-21 was measured at different time-points using
RT-qPCR (Fig. 1A). The expression
of miR-21 was upregulated following 1 day of differentiation and
peaked after 14 days. Subsequently, the levels of expression
gradually decreased, but remained upregulated for up to 28 days.
The mRNA levels of the ALP, OCN, Runx2 and OSX
osteogenic differentiation marker genes were significantly
increased at different time-points, indicating that the induction
of osteogenic differentiation was successful (Fig. 1B). These data suggested that miR-21
may be involved in osteogenic differentiation.
To investigate the role of miR-21 in regulating
osteoblast activity, the MC3T3-E1 cells were transfected with
mimic-NC, mimic-miR-21, inhibitor-NC or inhibitor-miR-21. The mRNA
expression levels of ALP, OCN, Runx2, and
OSX were significantly upregulated 48 h after mimic-miR-21
transfection and were downregulated at 48 h after inhibitor-miR-21
transfection compared with the controls, mimic-NC or inhibitor-NC
transfected cells (Fig. 2). The
mRNA expression levels of ALP, OCN, Runx2, and
OSX were consistently higher in the mimic-miR-21 group, and
consistently lower in the inhibitor-miR-21 treatment group at
different time-points during osteogenic differentiation, compared
with the corresponding control groups (Fig. 3).
 | Figure 2Reverse transcription-quantitative
polymerase chain reaction analysis of the mRNA levels of
ALP, OCN, RUNX2 and OSX in MC3T3-E1 cells
following treatment with 100 μM mimic-NC, mimic-miR-21,
inhibitor-NC or inhibitor-miR-21 for 48 h. Data are presented as
the mean ± standard deviation; *P<0.01 vs. control
group. miR, microRNA; NC, negative control; ALP, alkaline
phosphatase; OCN, osteocalcin; OSX, osterix;
RUNX2, Runt-related transcription factor 2. |
 | Figure 3Reverse transcription-quantitative
polymerase chain reaction analysis of changes in the mRNA
expression levels of (A) alkaline phosphatase, (B) osteocalcin, (C)
Runt-related transcription factor 2 and (D) osterix in MC3T3-E1
cells over time, following treatment with 100 μM mimic-NC,
mimic-miR-21, inhibitor-NC, or inhibitor-miR-21 in osteoblast
medium for 28 days. Data are presented as the mean ± standard
deviation. miR, microRNA; NC, negative control; ALP,
alkaline phosphatase, OCN, osteocalcin, RUNX2,
Runt-related transcription factor 2; OSX, osterix. |
The ARS revealed that transfection with the
mimic-miR-21 and inhibitor-miR-21 markedly increased and decreased
matrix mineralization, respectively (Fig. 4A). Transfection with the
mimic-miR-21 enhanced ALP staining, whereas inhibitor-miR-21
weakened ALP staining (Fig. 4B).
These data suggested that miR-21 promoted osteogenic
differentiation and mineralization.
Smad7 is a target of miR-21 in MC3T3-E1
cells
To further elucidate the mechanism by which miR-21
regulates osteoblast activity, the potential targets of miR-21 were
predicted using miRNA target analysis tools. Among the candidate
target genes, Smad7 was predicted as a target of miR-21
(Fig. 5A). To assess whether
miR-21 directly targets Smad7, luciferase reporters were
constructed with either a wild-type (WT) Smad7 3′-UTR or a
mutant (Mut) Smad7 3′-UTR, which contained a mutant miR-21
binding site sequence. The results of the luciferase activity
assays revealed that miR-21 significantly suppressed the activity
of the WT reporters, but not the Mut reporters, in the MC3T3-E1
cells (Fig. 5B).
During osteogenic differentiation, the levels of
miR-21 gradually increased (Fig.
6A) and the protein levels of SMAD7 decreased over time
(Fig. 6B). The overexpression of
miR-21 significantly suppressed the protein expression levels of
SMAD7, while inhibition of miR-21 elevated their levels in the
MC3T3-E1 cells (Fig. 7B). By
contrast, no differences were observed in the mRNA levels of
Smad7 between the groups (Fig.
7A). These results suggested that miR-21 negatively regulated
the protein expression of SMAD7.
miR-21 promotes osteogenic
differentiation and mineralization by targeting SMAD7
As miR-21 promoted osteogenic differentiation and
mineralization and downregulated levels of SMAD7, the present study
investigated whether the inhibition of Smad7 by siRNA
produced a similar effect in the MC3T3-E1 cells.
The effects of siRNA on the mRNA and protein levels
of Smad7 were confirmed using RT-qPCR (Fig. 8A) and western blot analysis
(Fig. 8B). The effects in the
MC3T3-E1 cells transfected with Smad7 siRNA were similar to
those observed in the cells transfected with mimic-miR-21 (Fig. 9). Following transfection of the
MC3T3-E1 cells with siRNA-Smad7, the mRNA levels of ALP,
OCN, RUNX2, and OSX remained higher compared
with the cells transfected with mimic-NC, mimic-miR-21,
inhibitor-NC or inhibitor-miR-21 (Fig. 10).
 | Figure 9Reverse transcription-quantitative
polymerase chain reaction analysis of ALP, OCN,
RUNX2, and OSX levels in MC3T3-E1 cells following
transfection with siRNA-Smad7 or siRNA-NC for 48 h. Data are
presented as the mean ± standard deviation; *P<0.01
vs. control group. siRNA, short interfering RNA; ALP,
alkaline phosphatase; OCN, osteocalcin; RUNX2,
Runt-related transcription factor 2; OSX, osterix; SMAD,
small mothers against decapentaplegic; NC, negative control. |
 | Figure 10Reverse transcription-quantitative
polymerase chain reaction analysis of the mRNA levels of (A)
ALP, (B) OCN, (C) RUNX2 and (D) OSX in
MC3T3-E1 cells following siRNA-Smad7 transfection with mimic-NC,
mimic-miR-21, inhibitor-NC or inhibitor-miR-21 for 48 h. Data are
presented as the mean ± standard deviation; *P<0.01
vs. control group. siRNA, short interfering RNA; NC, negative
control; ALP, alkaline phosphatase; OCN, osteocalcin;
RUNX2, Runt-related transcription factor 2; OSX,
osterix; SMAD, small mothers against decapentaplegic. |
The ARS revealed that siRNA-Smad7 markedly increased
matrix mineralization (Fig. 11A)
and enhanced ALP staining (Fig.
11B).
These results suggested that miR-21 promoted
osteogenic differentiation and mineralization in the MC3T3-E1
cells, in part, by inhibiting the mRNA expression of
Smad7.
Discussion
Previous studies have revealed that miRNAs are
essential in the regulation of osteogenic differentiation (2,15).
In the present study, the expression of miR-21 was significantly
increased during osteogenic differentiation in the MC3T3-E1 cells.
Furthermore, miR-21 was observed to be an active regulator of
osteogenic differentiation and mineralization, as the forced
expression of miR-21 promoted osteogenic differentiation and
mineralization, while inhibition of miR-21 suppressed these
processes. The present study also identified for the first time, to
the best of our knowledge, that miR-21 promoted osteogenic
differentiation and mineralization by repressing the expression of
Smad7.
miR-21 was the first miRNA to be identified as an
onco-microRNA. It is aberrantly expressed in several types of tumor
and acts as a tumor suppressor (16). It targets a number of essential
genes in certain types of cancer, including tongue squamous cell
carcinoma (17), thymic lymphoma
(18) and ovarian cancer (19), and is involved in tumor progression
and metastasis, specifically cell proliferation and
differentiation. Eguchi et al (20) hypothesized that miR-21 recognized
osteogenic differentiation-, stemness-, epigenetic-, and cell
cycle-associated mRNAs and was, therefore, designated as an
OstemiR. Yang et al (13)
revealed that miR-21 promotes mesenchymal stem cell osteogenesis by
repressing its target gene, sprouty homolog 1 (Spry1), and
confirmed the function of the miR-21-Spry1 axis by demonstrating
the promotion of bone formation in ovariectomized mice, in which
the TNF-α signal is inhibited. However, the role of miR-21 in
regulating osteogenic differentiation and mineralization remains to
be elucidated. The normal progression of osteogenic differentiation
is accompanied by expression of several marker genes, including
ALP, OCN, Runx2 and OSX. The present
study revealed that miR-21 was upregulated during the osteogenic
differentiation of the MC3T3-E1 cells. The osteogenic marker genes
were upregulated following overexpression of miR-21 and
downregulated following miR-21 inhibition. Mineralization was
enhanced by the overexpression of miR-21 and reduced by miR-21
inhibition. This evidence suggested that Smad7 is a
functional target of miR-21 and may mediate its regulatory role in
osteogenic differentiation and mineralization.
Smad7 is a critical regulator of TGF-β
signaling and its deregulation has been associated with various
diseases (21). It can potentially
inhibit BMP and TGF-β signals and is able to inhibit the
proliferation, differentiation and mineralization of mouse
osteoblastic cells (9). Wang et
al (22) revealed that
Collagen XXIV (Col24α1) interacts with integrin β3, and that
silencing Col24α1 upregulates the expression of Smad7 during
osteogenic differentiation. Several previous studies have
demonstrated miR-21-mediated downregulation of SMAD7 in
carcinoma-associated fibroblasts (23), scleroderma (24), myelodysplastic syndromes (25) and renal fibrosis (26). In the present study, bioinformatics
analysis combined with luciferase activity assays and western blot
analysis confirmed that Smad7 was a direct target of miR-21,
which explains the association between miR-21 and Smad7 in
regulating osteogenesis in MC3T3-E1 cells. The overexpression of
miR-21 affected the protein, but not the mRNA levels of SMAD7,
which suggested that miR-21 regulated the levels of SMAD7 by
inhibiting translation, rather than by promoting mRNA decay.
In conclusion, the present study demonstrated that
miR-21 promoted in vitro osteogenic differentiation and
mineralization by regulating Smad7. These results assist in
elucidating the potential molecular mechanism underlying the
regulation of bone formation. Furthermore, the association between
miR-21 and Smad7 in osteogenic differentiation and
mineralization has potential value in developing therapeutic
strategies to treat osteoporosis. Further in vivo
investigations are to be performed in ovariectomized mice.
Acknowledgments
The present study was funded by Shengjing Hospital
of China Medical University and Central Hospital of Shenyang
Medical College (Shenyang, China). The authors would like to thank
those who assisted in the preparation of the manuscript.
References
|
1
|
Moore BT and Xiao P: MiRNAs in bone
diseases. Microrna. 2:20–31. 2013. View Article : Google Scholar : PubMed/NCBI
|
|
2
|
Lian JB, Stein GS, van Wijnen AJ, Stein
JL, Hassan MQ, Gaur T and Zhang Y: MicroRNA control of bone
formation and homeostasis. Nat Rev Endocrinol. 8:212–227. 2012.
View Article : Google Scholar : PubMed/NCBI
|
|
3
|
Kureel J, Dixit M, Tyagi AM, Mansoori MN,
Srivastava K, Raghuvanshi A, Maurya R, Trivedi R, Goel A and Singh
D: miR-542-3p suppresses osteoblast cell proliferation and
differentiation, targets BMP-7 signaling and inhibits bone
formation. Cell Death Dis. 5:e10502014. View Article : Google Scholar : PubMed/NCBI
|
|
4
|
Lin X, Wu L, Zhang Z, Yang R, Guan Q, Hou
X and Wu Q: MiR-335-5p promotes chondrogenesis in mouse mesenchymal
stem cells and is regulated through two positive feedback loops. J
Bone Miner Res. 29:1575–1585. 2014. View Article : Google Scholar
|
|
5
|
Vimalraj S, Partridge NC and Selvamurugan
N: A Positive Role of microRNA-15b on regulation of osteoblast
differentiation. J Cell Physiol. 29:1236–1244. 2014. View Article : Google Scholar
|
|
6
|
Chen G, Deng C and Li YP: TGF-β and BMP
signaling in osteoblast differentiation and bone formation. Int J
Biol Sci. 8:272–288. 2012. View Article : Google Scholar
|
|
7
|
Lei Z, Xu G, Wang L, Yang H, Liu X, Zhao J
and Zhang HT: MiR-142-3p represses TGF-β-induced growth inhibition
through repression of TGFβR1 in non-small cell lung cancer. FASEB
J. 28:2696–2704. 2014. View Article : Google Scholar : PubMed/NCBI
|
|
8
|
Cao S, Xiao L, Rao JN, Zou T, Liu L, Zhang
D, Turner DJ, Gorospe M and Wang JY: Inhibition of Smurf2
translation by miR-322/503 modulates TGF-β/Smad2 signaling and
intestinal epithelial homeostasis. Mol Biol Cell. 25:1234–1243.
2014. View Article : Google Scholar : PubMed/NCBI
|
|
9
|
Yano M, Inoue Y, Tobimatsu T, Hendy G,
Canaff L, Sugimoto T, Seino S and Kaji H: Smad7 inhibits
differentiation and mineralization of mouse osteoblastic cells.
Endocr J. 59:653–662. 2012. View Article : Google Scholar : PubMed/NCBI
|
|
10
|
Kupczyk M and Kuna P: MicroRNAs-new
biomarkers of respiratory tract diseases. Pneumonol Alergol Pol.
82:183–190. 2014.In Polish. View Article : Google Scholar
|
|
11
|
Fan X, Wang E, Wang X, Cong X and Chen X:
MicroRNA-21 is a unique signature associated with coronary plaque
instability in humans by regulating matrix metalloproteinase-9 via
reversion-inducing cysteine-rich protein with Kazal motifs. Exp Mol
Pathol. 96:242–249. 2014. View Article : Google Scholar : PubMed/NCBI
|
|
12
|
Liu H, Huang X, Liu X, Xiao S, Zhang Y,
Xiang T, Shen X, Wang G and Sheng B: mir-21 promotes human nucleus
pulposus cell proliferation through PTEN/AKT signaling. Int J Mol
Sci. 15:4007–4018. 2014. View Article : Google Scholar : PubMed/NCBI
|
|
13
|
Yang N, Wang G, Hu C, Shi Y, Liao L, Shi
S, Cai Y, Cheng S, Wang X, Liu Y, Tang L, et al: Tumor necrosis
factor α suppresses the mesenchymal stem cell osteogenesis promoter
miR-21 in estrogen deficiency-induced osteoporosis. J Bone Miner
Res. 28:559–573. 2013. View Article : Google Scholar
|
|
14
|
Yuan JS, Reed A, Chen F and Stewart CN Jr:
Statistical analysis of real-time PCR data. BMC Bioinformatics.
7:852006. View Article : Google Scholar : PubMed/NCBI
|
|
15
|
van Wijnen AJ, van de Peppel J, van
Leeuwen JP, et al: MicroRNA functions in osteogenesis and
dysfunctions in osteoporosis. Curr Osteoporos Rep. 11:72–82. 2013.
View Article : Google Scholar : PubMed/NCBI
|
|
16
|
Salaun B, Yamamoto T, Badran B, et al:
Differentiation associated regulation of microRNA expression in
vivo in human CD8+ T cell subsets. J Transl Med. 9:442011.
View Article : Google Scholar : PubMed/NCBI
|
|
17
|
Ren W, Wang X, Gao L, Li S, Yan X, Zhang
J, Huang C, Zhang Y and Zhi K: MiR-21 modulates chemosensitivity of
tongue squamous cell carcinoma cells to cisplatin by targeting
PDCD4. Mol Cell Biochem. 390:253–262. 2014. View Article : Google Scholar : PubMed/NCBI
|
|
18
|
Liu C, Li B, Cheng Y, Lin J, Hao J, Zhang
S, Mitchel RE, Sun D, Ni J, Zhao L, Gao F, et al: MiR-21 plays an
important role in radiation induced carcinogenesis in BALB/c mice
by directly targeting the tumor suppressor gene Big-h3. Int J Biol
Sci. 7:347–363. 2011. View Article : Google Scholar : PubMed/NCBI
|
|
19
|
Chan JK, Blansit K, Kiet T, Sherman A,
Wong G, Earle C and Bourguignon LY: The inhibition of miR-21
promotes apoptosis and chemosensitivity in ovarian cancer. Gynecol
Oncol. 132:739–744. 2014. View Article : Google Scholar : PubMed/NCBI
|
|
20
|
Eguchi T, Watanabe K, Hara ES, Ono M,
Kuboki T and Calderwood SK: OstemiR: a novel panel of microRNA
biomarkers in osteoblastic and osteocytic differentiation from
mesencymal stem cells. PLoS One. 8:e587962013. View Article : Google Scholar : PubMed/NCBI
|
|
21
|
Luo L, Li N, Lv N and Huang D: SMAD7: a
timer of tumor progression targeting TGF-β signaling. Tumour Biol.
35:8379–8385. 2014. View Article : Google Scholar : PubMed/NCBI
|
|
22
|
Wang W, Olson D, Liang G, Franceschi RT,
Li C, Wang B, Wang SS and Yang S: Collagen XXIV (Col24α1) promotes
osteoblastic differentiation and mineralization through TGF-β/Smads
signaling pathway. Int J Biol Sci. 8:1310–1322. 2012. View Article : Google Scholar
|
|
23
|
Li Q, Zhang D, Wang Y, Sun P, Hou X,
Larner J, Xiong W and Mi J: MiR-21/Smad 7 signaling determines
TGF-β1-induced CAF formation Sci Rep. 3:20382013.
|
|
24
|
Zhu H, Luo H, Li Y, Zhou Y, Jiang Y, Chai
J, Xiao X, You Y and Zuo X: MicroRNA-21 in scleroderma fibrosis and
its function in TGF-β-regulated fibrosis-related genes expression.
J Clin Immunol. 33:1100–1109. 2013. View Article : Google Scholar : PubMed/NCBI
|
|
25
|
Bhagat TD, Zhou L, Sokol L, et al: miR-21
mediates hematopoietic suppression in MDS by activating TGF-β
signaling. Blood. 121:2875–2881. 2013. View Article : Google Scholar : PubMed/NCBI
|
|
26
|
Chung AC, Dong Y, Yang W, Zhong X, Li R
and Lan HY: Smad7 suppresses renal fibrosis via altering expression
of TGF-β/Smad3-regulated microRNAs. Mol Ther. 21:388–398. 2013.
View Article : Google Scholar :
|